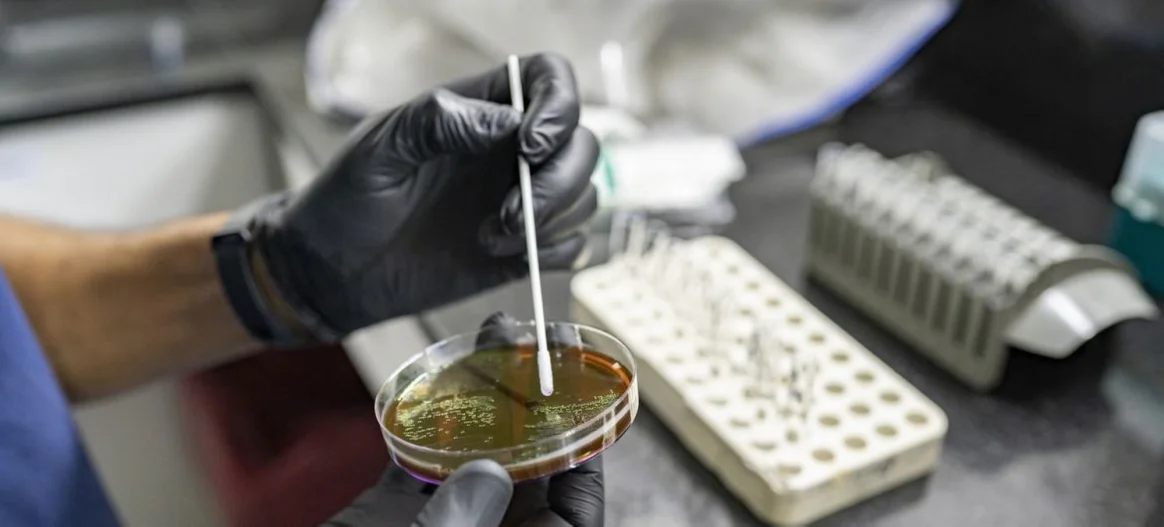

حذرت منظمة الصحة العالمية من ارتفاع مقاومة مضادات الميكروبات بنسبة 40% بين عامي 2018 و2023، ما يشكل تهديدًا متزايدًا للصحة العالمية.
وأوضح تقريرها أن واحدة من كل 6 عدوى بكتيرية مؤكدة مختبريًا أصبحت مقاومة للمضادات الحيوية، بما يشمل 22 نوعًا من المضادات المستخدمة في علاج أمراض شائعة مثل التهابات المسالك البولية والجهاز الهضمي ومجرى الدم والسيلان.
ويغطي التقرير 8 مسببات بكتيرية شائعة، منها الإشريكية القولونية، والراكدة، والكلبسيلة الرئوية، والنيسلية البنية، والسالمونيلا غير التيفية، والشيغيلا، والمكورات العنقودية الذهبية، والعقدية الرئوية. وفق “أخبار 24”.
وأكد المدير العام للمنظمة، د. تيدروس أدهانوم، أن مقاومة المضادات الحيوية تتجاوز التقدم الطبي الحديث، داعيًا إلى تعزيز أنظمة المراقبة، وترشيد استخدام المضادات، وتطوير جيل جديد من المضادات الحيوية والاختبارات السريعة.